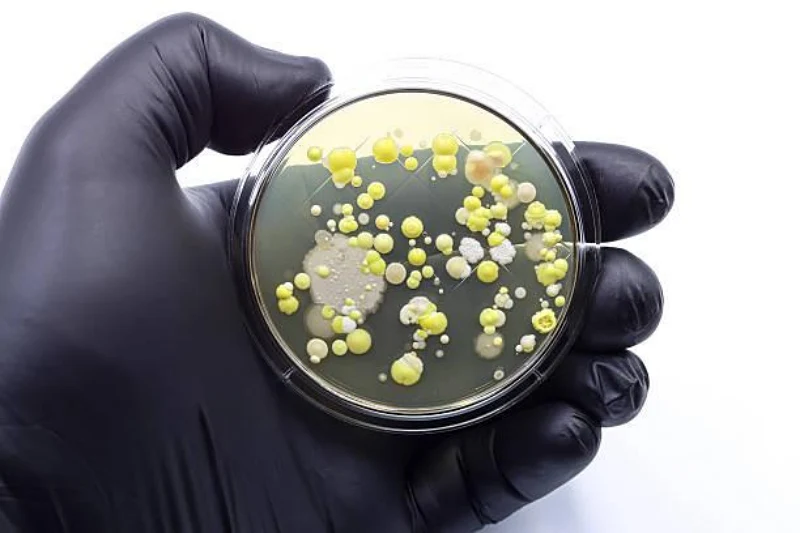
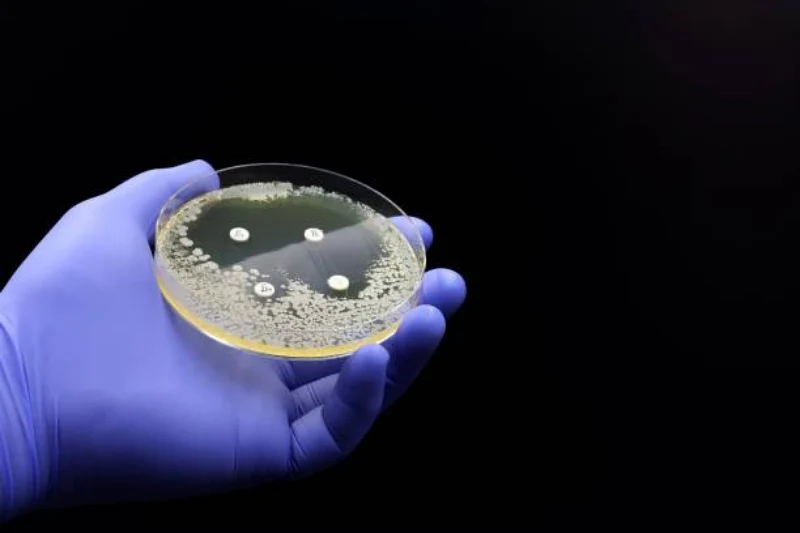

Galeria de imagens - Análise microbiológica de superfícies
A Importância da análise microbiológica de superfícies
A análise microbiológica de superfícies desempenha um papel fundamental na garantia da qualidade e segurança em diversos setores, como indústrias alimentícias, cozinhas industriais, hospitais e farmácias.
Por meio da Análise de Superfície (SWAB), é possível verificar a eficácia da higienização, controlar contaminações cruzadas e assegurar a adoção de boas práticas de limpeza.
Como Funciona a análise microbiológica de superfícies?
A Análise de Superfície consiste na aplicação de swabs estéreis em áreas críticas, seguida da coleta de amostras para análise microbiológica.
Durante o processo, são identificados microrganismos como coliformes, E. coli, Staphylococcus aureus, entre outros, a fim de avaliar a qualidade da higienização das superfícies e prevenir possíveis riscos à saúde.
Vantagens da análise microbiológica de superfícies
A análise microbiológica de superfícies oferece diversas vantagens, como a garantia de ambientes limpos e livres de contaminação, a identificação precoce de possíveis fontes de infecção, o cumprimento de normas sanitárias e a promoção de uma imagem positiva para o estabelecimento.
Além disso, os resultados claros e a interpretação especializada proporcionam a elaboração de um plano de ação eficaz para a manutenção da higiene e segurança do local.
Control Análises: Especialista em Análises Ambientais
O Control Análises é referência no mercado de análises ambientais desde 2012, oferecendo serviços técnicos e laboratoriais de alta qualidade em áreas como água, efluentes, esgoto, alimentos e solo.
Com certificações internacionais e reconhecimento pelo escopo acreditado na área ambiental, a empresa se destaca pela excelência e confiabilidade de seus serviços em todo o Brasil.
Conte com o Control Análises para análise microbiológica de superfícies!
Se você busca uma empresa especializada em análise microbiológica de superfícies, o Control Análises é a escolha certa.
Com uma equipe qualificada, tecnologia de ponta e experiência comprovada, garantimos resultados precisos, confiáveis e com interpretação clara para a implementação de ações corretivas e preventivas.
Entre em contato conosco e conheça mais sobre nossos serviços e soluções personalizadas para atender às suas necessidades.